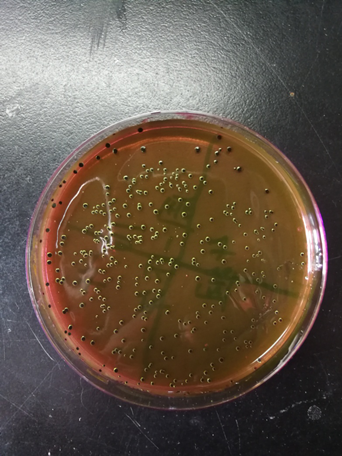

微生物学实验课程简介:
课程名称:微生物学实验
任课教师:王祥红
选课人数:170人/年
学时数:32学时
课程类型:实践(必修)
适用专业:生物科学、生物技术、生态学
微生物学是一门实践性很强的学科,本课程是与微生物学理论教学相配套的实验教学,目的是训练学生掌握微生物学最基本的实验操作技能,了解微生物学的基本知识,加深理解课堂讲授的微生物学理论知识,同时,通过实验培养学生观察、思考、分析问题和解决问题的能力;实事求是,严肃认真的科学态度。实验课程内容包括:学会普通光学显微镜的使用方法,特别是显微镜油镜的使用方法、学会微生物的制片染色技术、学会微生物细胞的大小测量技术及数量计数技术、学会培养基的制备、灭菌及微生物的分离纯化技术、学会鉴定细菌的常规生理生化实验方法。
微生物学实验的教学目的,是通过课程的学习加深和巩固所学的理论知识,掌握必要的微生物实验技能,培养学生独立观察、思考、分析、提出和解决问题的能力,在实验中提高学生的科学素养。
实验内容分为两大部分,第一部分是与植物生物学实验和动物生物学实验相关的形态观察部分,包括显微镜及油浸物镜的使用方法,学生必须学会显微镜油镜的使用方法,使其在下一步的实验中熟练掌握,以便观察各种形态的微生物;细菌的革兰氏染色、芽孢染色是观察微生物形态的基本染色技术;实验课中设计了对细菌、放线菌、酵母、霉菌等微生物的形态观察使学生对不同微生物的形态特征有直观的了解;实验中的死活细胞鉴别实验可以使学生了解死活细胞鉴别的特殊染色技术;血球计数板的使用实验使学生学会计数微生物细胞数量的显微镜直接计数法;微生物大小的测定技术使学生学会使用显微镜、目镜测微尺和镜台测微尺测量微生物细胞的大小。
第二部分是综合性实验,微生物的各种无菌操作技术是微生物实验中基本的技术要求,贯穿于实验课的始终;实验的基本思路是设计两个综合实验,把微生物学实验的基本操作包含在其中,又充分调动学生学习的积极性、主动性和创造性,包括:培养基的配制及灭菌实验使学生学会配制培养基的基本方法和灭菌的方法;环境中微生物的分离和纯化实验,让学生学习分离微生物的方法、纯化微生物的方法;环境中的微生物实验让学生初步了解常见环境和体表的微生物种类和形态;水中细菌总数和大肠菌群数的测定学习水中细菌总数和大肠菌群数的测定方法;细菌鉴定常用生理生化反应实验是为了学习常用细菌的生理生化鉴定方法。综合实验室学生在学习基本微生物实验操作技术的基础过程中自主查阅相关文献、自主设计实验内容下进行的实验,以提高学生的自主创新能力。

进行实验
实验现象:

细菌芽孢




酵母菌

大肠菌群

吲哚产生实验
